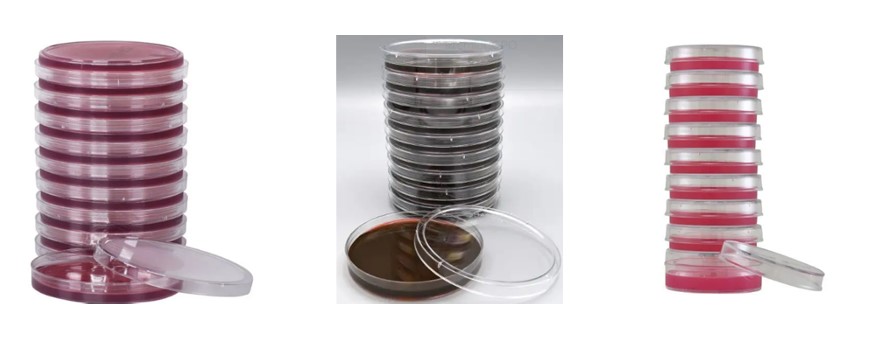

Ágar MacConkey – Placa 60×15 mm ou 90×15 mm
O Ágar MacConkey é um meio de cultura seletivo e diferencial utilizado para o isolamento de bactérias Gram-negativas, especialmente da família Enterobacteriaceae. Ele permite diferenciar microrganismos fermentadores de lactose, que formam colônias rosadas ou avermelhadas, daqueles não fermentadores, que apresentam colônias incolores. É amplamente utilizado em análises clínicas, microbiologia de alimentos, água e controle de qualidade.
Ágar Eosina Azul de Metileno (EMB) – Placa 60×15 mm ou 90×15 mm
O Ágar EMB é um meio de cultura seletivo e diferencial indicado para o isolamento e identificação de bactérias entéricas Gram-negativas. Os corantes eosina e azul de metileno inibem bactérias Gram-positivas e auxiliam na diferenciação das colônias. Bactérias fermentadoras de lactose produzem colônias escuras ou com brilho metálico característico, como ocorre frequentemente com Escherichia coli. O meio é muito utilizado em análises de água, alimentos e amostras clínicas.
Ágar Endo C (Endo Agar) – Placa 60×15 mm ou 90×15 mm
O Ágar Endo é um meio de cultura seletivo utilizado para a detecção de coliformes e bactérias Gram-negativas fermentadoras de lactose. Nesse meio, microrganismos que fermentam lactose formam colônias vermelhas com brilho metálico, enquanto os não fermentadores permanecem incolores ou pálidos. É amplamente aplicado em análises microbiológicas de água, alimentos e controle sanitário, sendo um meio importante para avaliação da qualidade microbiológica.